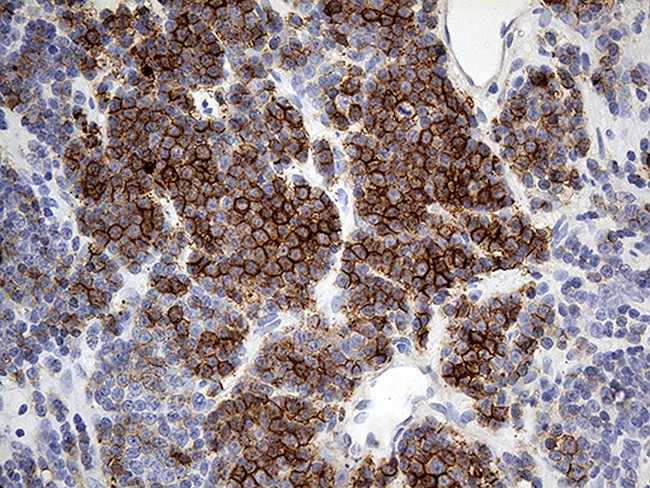
HLA Antibody in Immunohistochemistry (Paraffin) (IHC (P))

Search
OriGene
HLA Monoclonal Antibody (OTI4G7), TrueMAB™
{{$productOrderCtrl.translations['antibody.pdp.commerceCard.promotion.promotions']}}
{{$productOrderCtrl.translations['antibody.pdp.commerceCard.promotion.viewpromo']}}
{{$productOrderCtrl.translations['antibody.pdp.commerceCard.promotion.promocode']}}: {{promo.promoCode}} {{promo.promoTitle}} {{promo.promoDescription}}. {{$productOrderCtrl.translations['antibody.pdp.commerceCard.promotion.learnmore']}}
产品信息
TA812174
种属反应
宿主/亚型
分类
类型
克隆号
抗原
偶联物
形式
浓度
规格
纯化类型
保存液
内含物
保存条件
运输条件
靶标信息
HLA-DRB5 belongs to the HLA class II beta chain paralogues. This class II molecule is a heterodimer consisting of an alpha (DRA) and a beta (DRB) chain, both anchored in the membrane. It plays a central role in the immune system by presenting peptides derived from extracellular proteins. Class II molecules are expressed in antigen presenting cells (APC: B lymphocytes, dendritic cells, macrophages). The beta chain is approximately 26-28 kDa and its gene contains 6 exons. Exon one encodes the leader peptide, exons 2 and 3 encode the two extracellular domains, exon 4 encodes the transmembrane domain and exon 5 encodes the cytoplasmic tail. Within the DR molecule the beta chain contains all the polymorphisms specifying the peptide binding specificities. Typing for these polymorphisms is routinely done for bone marrow and kidney transplantation. DRB1 is expressed at a level five times higher than its paralogues DRB3, DRB4 and DRB5. The presence of DRB5 is linked with allelic variants of DRB1, otherwise it is omitted. There are 4 related pseudogenes: DRB2, DRB6, DRB7, DRB8 and DRB9.
HLA and MHC antibodies play a significant role in Immunopeptidomics, facilitating the identification and characterization of neoantigens through high-performance liquid chromatography coupled to tandem Mass Spectrometry.
仅用于科研。不用于诊断过程。未经明确授权不得转售。
篇参考文献 (0)
生物信息学
蛋白别名: DR beta-5; DR2-beta-2; DRB1; DRB1-9 beta chain; Dw2; ERLA-005; HLA class II histocompatibility antigen, DR beta 5 chain; HLA class II histocompatibility antigen, DR-5 beta chain; hla-dr5; HLA-DRB1; human leucocyte antigen; MHC class II antigen DRB5; MHC HLA-DR; MHC HLA-DR-beta chain; MHC HLA-DR-beta chain precursor; MHC HLA-DR-beta chain precursor old gene name 'HLA-DRA1'; MHC HLA-DR-beta surface glycoprotein; MHC HLA-DR-beta-1 precursor; MHC HLA-DR2(Dw12)a glycoprotein beta-chain; MHC HLA-DR2(Dw2)a glycoprotein beta-chain; MHC HLA-DR2(non-Dw2/non-Dw12)a glycoprotein beta-chain; unnamed protein product
基因别名: DRB5; HLA-DRB5; HLA-DRB5*
UniProt ID: (Human) Q30154
Entrez Gene ID: (Human) 3127